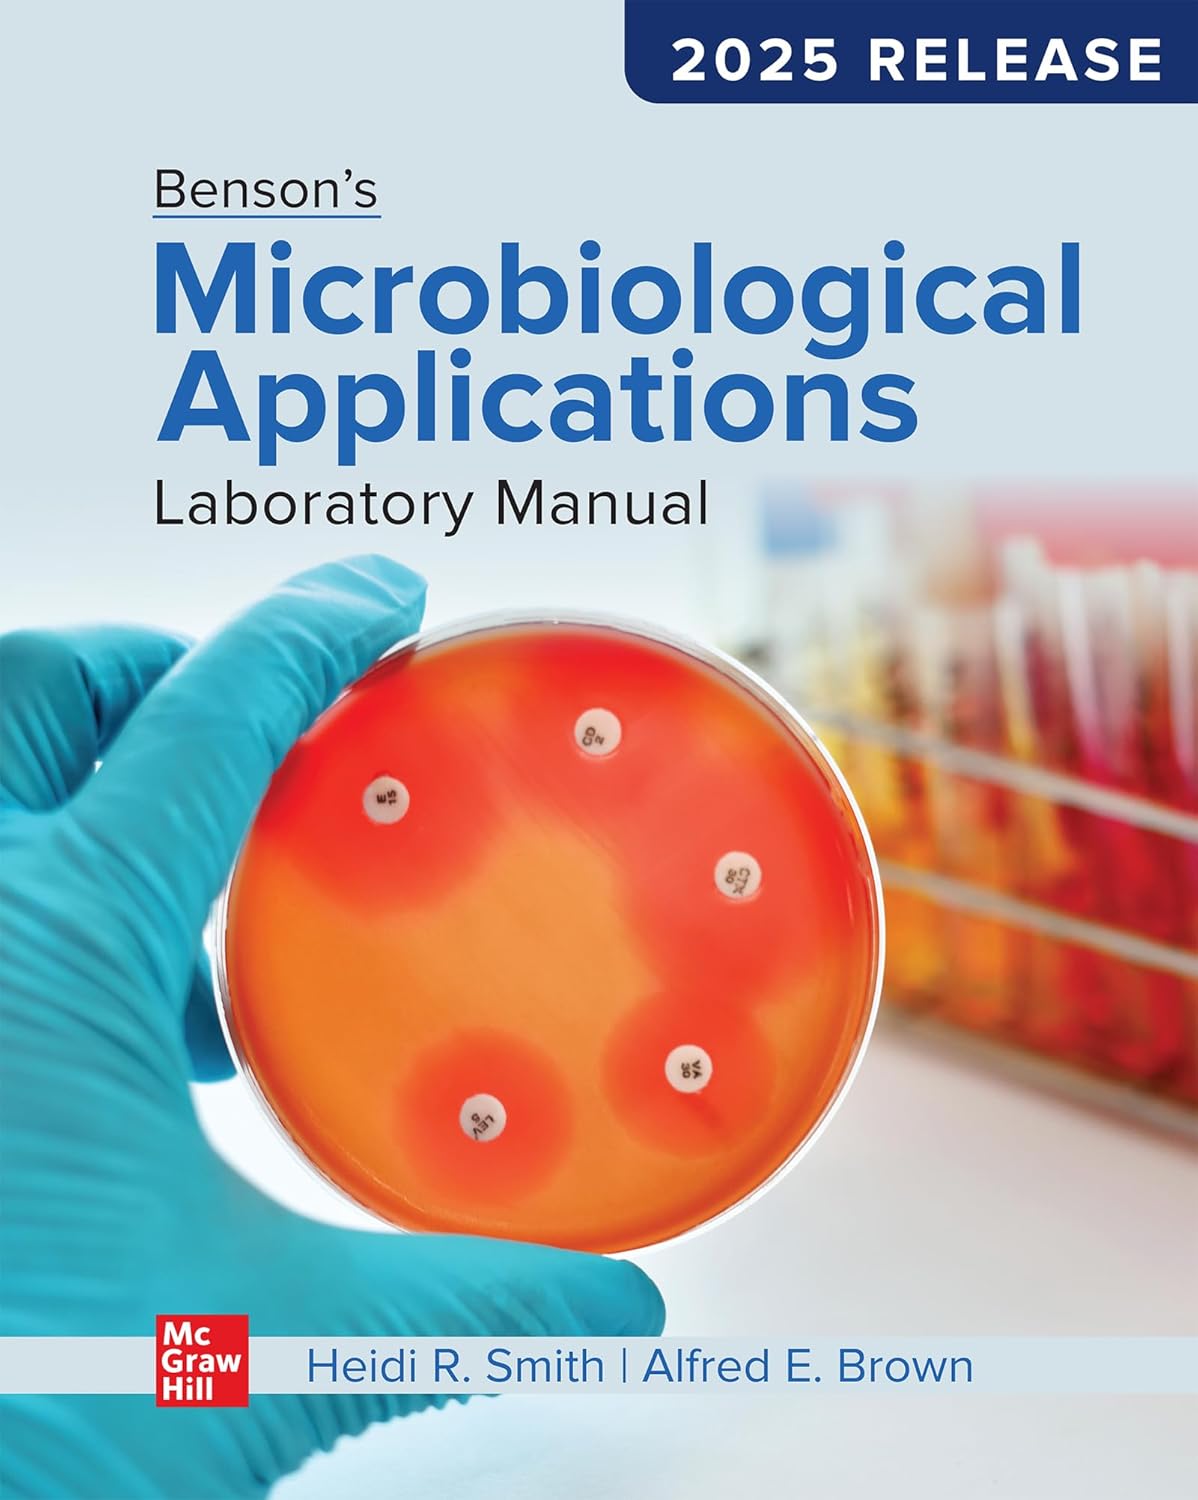

Benson’s Microbiological Applications Laboratory Manual: 2025 Release – PDF ebook
USD $29.99
| Author | Heidi Smith, Alfred Brown |
|---|---|
| Publisher | McGraw-Hill Higher Education |
| Edition/Release | 2025 |
| Copyright | 2025 |
| ISBN | 9781260425543, 9781264585106 |
| Format |
| Please note: | eBooks do Not come with: Access Code, Paper Book, Audiobook, CDs/DVDs, and other supplemental items. |
|---|
No Waiting: Your download link is available immediately after purchase.
- Save up to 80% by choosing the PDF eBook
- High-quality searchable PDF format, ideal for printing
- No expiration date! No DRM protection
- Direct download method